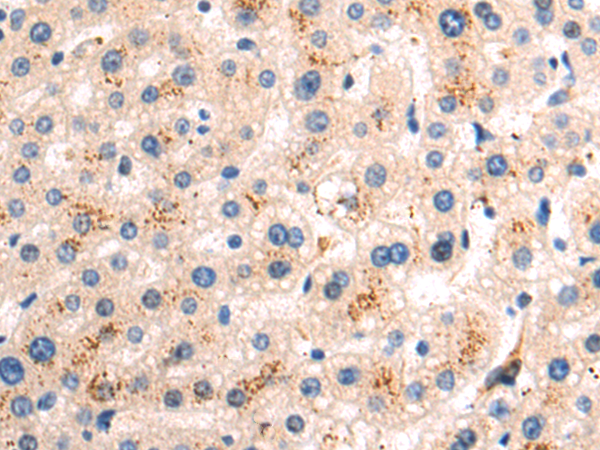
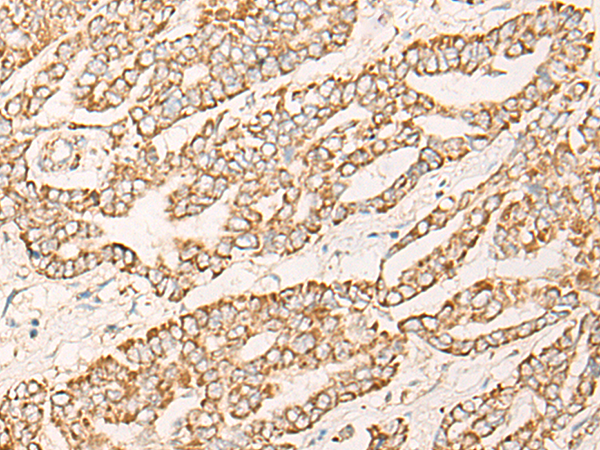

-
分类: 科研抗体货号: P06351别名: DABP应用: IHC反应种属: Human, Mouse, Rat
-
分类: 科研抗体货号: P06310别名: AD3; FAD; PS1; PS-1; S182; ACNINV3应用: WB,IHC反应种属: Human, Mouse
-
分类: 科研抗体货号: P06237别名: DSS; GAS3; HNPP; CMT1A; CMT1E; GAS-3; Sp110; HMSNIA应用: WB,IHC反应种属: Human, Mouse
-
分类: 科研抗体货号: P06348别名:应用: WB,IHC反应种属: Human, Mouse
-
分类: 科研抗体货号: P06309别名:应用: WB,IHC反应种属: Human, Mouse, Rat
-
分类: 科研抗体货号: P06234别名: E1AF; PEA3; E1A-F; PEAS3应用: IHC反应种属: Human, Mouse
-
分类: 科研抗体货号: P06342别名: CPAD; CYP2A; CYPIIA13应用: WB,IHC反应种属: Human
-
分类: 科研抗体货号: P06308别名: PIP1; PTOP; TPP1; TINT1应用: IHC反应种属: Human, Mouse, Rat
-
分类: 科研抗体货号: P06323别名: GRF; INN; GHRF应用: IHC反应种属: Human
-
分类: 科研抗体货号: P06332别名: COX4; COX4B; COX4-2; COX4L2; COXIV-2; dJ857M17.2应用: IHC反应种属: Human

鄂公网安备42018502007531号
鄂公网安备42018502007531号

